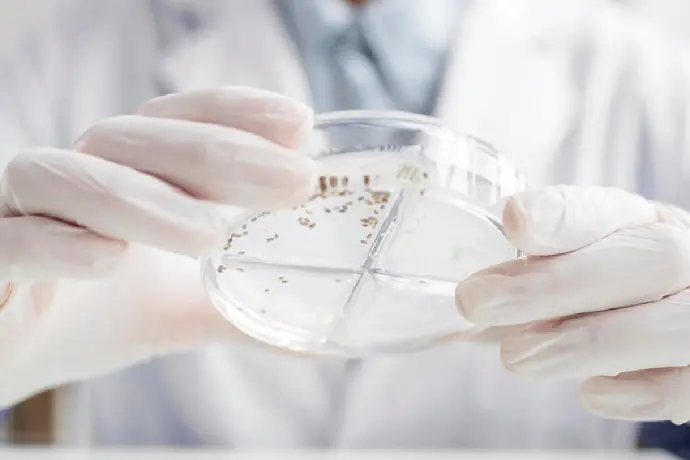

DỊCH VỤ THIẾT KẾ, THI CÔNG HỆ THỐNG XỬ LÝ NƯỚC THẢI NHA KHOA
Giải Pháp Bảo Vệ Môi Trường Và Sức Khỏe Cộng Đồng

TƯ VẤN CHUYÊN NGHIỆP
Đội ngũ tư vấn dịch vụ chuyên nghiệp với kinh nghiệm hơn 10 năm

KHÔNG PHÁT SINH CHI PHÍ
Cam kết không phát sinh chi phí khi đã báo giá cho doanh nghiệp
TẦM QUAN TRỌNG CỦA HỆ THỐNG XỬ LÝ NƯỚC THẢI NHA KHOA
Nước thải từ các phòng khám nha khoa chứa nhiều chất ô nhiễm đặc thù như hóa chất, thuốc kháng sinh, vi khuẩn, virus, các kim loại nặng (như thủy ngân từ amalgam) và các chất thải sinh học khác. Nếu không được xử lý đúng cách, nước thải này có thể gây ô nhiễm nghiêm trọng đến nguồn nước, làm ảnh hưởng đến sức khỏe cộng đồng và môi trường. Vì thế, việc lắp đặt hệ thống xử lý nước thải nha khoa đạt chuẩn là bắt buộc đối với mỗi cơ sở nha khoa, theo quy định của Luật Bảo vệ Môi trường.

DỊCH VỤ THIẾT KẾ, THI CÔNG HỆ THỐNG XỬ LÝ NƯỚC THẢI NHA KHOA
SGC cung cấp giải pháp toàn diện cho hệ thống xử lý nước thải nha khoa với các dịch vụ thiết kế, thi công và hỗ trợ vận hành, đảm bảo hiệu quả xử lý cao, đáp ứng các tiêu chuẩn về môi trường.

1. Khảo sát và tư vấn hệ thống xử lý phù hợp
- SGC sẽ khảo sát trực tiếp tại phòng khám để đánh giá lượng nước thải, thành phần chất thải và các yếu tố đặc thù của từng cơ sở nha khoa. Dựa trên kết quả khảo sát, chúng tôi tư vấn phương án thiết kế tối ưu, phù hợp với nhu cầu và diện tích phòng khám .

2. Thiết kế hệ thống xử lý nước thải nha khoa
- Lựa chọn công nghệ xử lý: Dựa vào đặc thù của nước thải nha khoa, hệ thống xử lý sẽ bao gồm các giai đoạn cơ bản như lọc rác, tách kim loại nặng, xử lý sinh học và khử trùng. SGC thiết kế hệ thống theo tiêu chuẩn an toàn, tiết kiệm diện tích, dễ vận hành và chi phí hợp lý.
- Đảm bảo hiệu suất xử lý cao: Hệ thống được thiết kế để loại bỏ các chất ô nhiễm như BOD, COD, kim loại nặng và vi khuẩn, đảm bảo nước sau xử lý đạt chuẩn xả thải theo quy định pháp luật.

3. Thi công và lắp đặt hệ thống xử lý
- Thi công chuyên nghiệp: Đội ngũ kỹ thuật của SGC thực hiện thi công và lắp đặt hệ thống xử lý theo đúng bản vẽ thiết kế, đảm bảo an toàn, thẩm mỹ và không làm gián đoạn hoạt động của phòng khám.
- Kiểm tra và vận hành thử: Sau khi hoàn thành lắp đặt, hệ thống sẽ được kiểm tra và vận hành thử để đảm bảo hiệu quả xử lý trước khi bàn giao cho khách hàng.

4. Hướng dẫn vận hành và bảo trì
-
SGC cung cấp hướng dẫn chi tiết về cách vận hành và bảo trì hệ thống cho nhân viên phòng khám, đảm bảo hệ thống hoạt động liên tục và hiệu quả. Ngoài ra, chúng tôi cung cấp dịch vụ bảo trì định kỳ, kiểm tra và xử lý sự cố nhanh chóng nếu phát sinh.
CÔNG NGHỆ XỬ LÝ NƯỚC THẢI NHA KHOA TẠI SGC
Hệ thống xử lý nước thải nha khoa của SGC sử dụng công nghệ xử lý tích hợp, tối ưu hóa hiệu suất và đảm bảo tính an toàn:

Bể lọc sơ cấp
Tách các chất rắn, vụn rác, máu và các chất thải y tế lơ lửng
.

Xử lý hóa học
Tách và loại bỏ các kim loại nặng, như thủy ngân từ amalgam, giúp giảm thiểu rủi ro ô nhiễm cho nước và đất.
Xử lý sinh học
Sử dụng các vi sinh vật để phân hủy các chất hữu cơ như BOD và COD, giảm tải lượng chất ô nhiễm.

Khử trùng
Xử lý vi sinh vật và vi khuẩn gây bệnh, đảm bảo nước sau xử lý không chứa tác nhân gây hại và đạt chuẩn an toàn xả thải.
TẠI SAO NÊN CHỌN SGC LÀ ĐỐI TÁC XỬ LÝ NƯỚC THẢI NHA KHOA
SGC là đơn vị uy tín trong lĩnh vực môi trường với kinh nghiệm nhiều năm cung cấp giải pháp xử lý nước thải cho các cơ sở y tế, phòng khám nha khoa trên cả nước. Các lợi ích khi chọn SGC bao gồm:
Đội ngũ kỹ thuật viên giàu kinh nghiệm
Các kỹ sư môi trường của SGC có trình độ chuyên môn cao, am hiểu quy định và tiêu chuẩn xử lý nước thải y tế .
Công nghệ xử lý tiên tiến
SGC áp dụng công nghệ xử lý nước thải hiện đại, tối ưu hóa hiệu suất và thân thiện với môi trường.
Dịch vụ trọn gói và bảo hành dài hạn
Từ khảo sát, thiết kế, thi công đến bảo hành, bảo trì, SGC cung cấp dịch vụ trọn gói, đảm bảo khách hàng yên tâm sử dụng.
Tư vấn và hỗ trợ kỹ thuật tận tâm
SGC cam kết đồng hành cùng phòng khám trong suốt quá trình vận hành, cập nhật các quy định pháp luật và hỗ trợ kỹ thuật kịp thời khi cần thiết.
LỢI ÍCH CỦA HỆ THỐNG XỬ LÝ NƯỚC THẢI NHA KHOA
Đảm bảo tuân thủ pháp luật
Hệ thống xử lý nước thải nha khoa giúp các phòng khám tuân thủ quy định của Luật Bảo vệ Môi trường, tránh các hình thức xử phạt hành chính.
Bảo vệ môi trường và sức khỏe cộng đồng
Xử lý nước thải đúng cách giúp ngăn ngừa ô nhiễm nguồn nước và bảo vệ sức khỏe cho cộng đồng, người lao động và khách hàng tại phòng khám
Nâng cao uy tín và hình ảnh phòng khám
Thực hiện tốt công tác xử lý nước thải góp phần xây dựng uy tín và niềm tin của khách hàng, thể hiện trách nhiệm với xã hội.
Tối ưu chi phí vận hành
Hệ thống xử lý nước thải nha khoa của SGC được thiết kế tối ưu, tiết kiệm chi phí vận hành và bảo trì, giúp phòng khám hoạt động ổn định và hiệu quả
.
Liên Hệ Ngay Với SGC Để Được Tư Vấn Miễn Phí!
SGC cam kết đồng hành cùng doanh nghiệp, mang đến những giải pháp toàn diện và hiệu quả nhất về thiết kế thi công hệ thống xử lý nước thải và khí thải. Hãy liên hệ với chúng tôi để được tư vấn và hỗ trợ tốt nhất!
ĐƠN VỊ THỰC HIỆN DỊCH VỤ
QUAN TRẮC MÔI TRƯỜNG ĐỊNH KỲ
CÔNG TY CP DỊCH VỤ CÔNG NGHỆ SÀI GÒN
Địa chỉ: Tầng 14, Tòa nhà HM Town, 412 Nguyễn Thị Minh Khai, P.5, Quận 3, TP.HCM.
VPĐD: 65/17 Đường Nguyễn Thị Xinh (TA21 cũ), P.Thới An, Quận 12, TP.HCM.
VP Hà Nội: 08-DG2, 125 phố Đại Linh, P. Trung Văn, Nam Từ Liêm, Hà Nội.
Hotline: 098 670 9307
Email: info@hsevn.com.vn